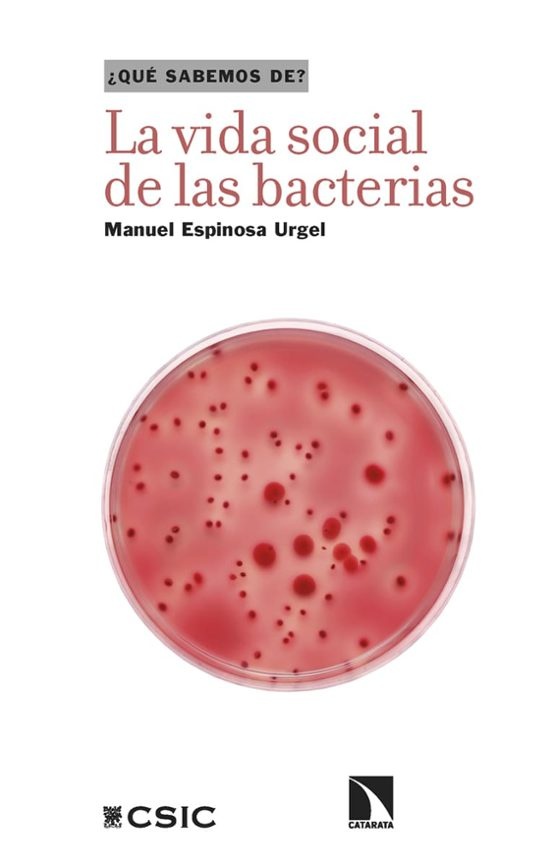
La vida social de las bacterias

X
Precio
+
$ 8000 - $ 12000
$ 12000 - $ 20000
$ 20000 - $ 35000
$ 31000 - $ 45000
$ 46000 - $ 150000
$ 150000 +
Eliminar filtros
Aplicar filtros



Martti Nissinen
La profecía en la antigüedad
$113.135
$101.822 


Helen Czerski
La máquina azul
$45.699
$41.130 


Federico Miyara
Acústica y sistemas de sonido
$47.000
$42.300 


López, Guevara y otros
Los alimentos mágicos de las culturas indígenas mesoamericanas
$33.000
$29.700 


Feynman, Leighton y otros
Lecciones de física de Feynman I
$79.000
$71.100 


Weinersmith, Weinersmith
Una ciudad en Marte
$49.999
$45.000 


Alain Aspect
Si Einstein lo hubiera sabido
$45.699
$41.130 


Cabezas, Acosta
Cacapedia
$28.000
$25.200 


Paul Strathern
Bohr y la teoría cuántica
$20.900
$18.810 


Tarancon, Valle
Premoniciones
$37.000
$33.300 


Manuel Espinosa Urgel
La vida social de las bacterias
$28.000
$25.200 


Analía Furio
Mal dormidos
$39.900
$35.910 


Hebe Vessuri
Conocimientos, sociedades y tecnologías en América Latina
$29.000
$26.100 


Fernando Valladares
Las pandemias
$27.100
$24.390 


Mercedes Ferrer Gijón
Megatsunamis
$29.800
$26.820 


Pedro Meseguer
Ficciones con ciencia
$33.900
$30.510 


Lucy Cooke
Hembras
$49.500
$44.550 


Castro, Huertas
La ciencia y la cocina
$29.800
$26.820 


Elena Campos Sanchez
Que sabemos de nuestro sistema inmunitario
$29.800
$26.820 


Cat Bohannon
Eva
$59.900
$53.910 


Gabriela Arriagada
Los sesgos del algoritmo
$20.000
$18.000 


Matthew Cobb
Una historia de la idea del cerebro
$40.900
$36.810 


Carlos Pedros-Alio
Biodiversidad
$40.700
$36.630 


Elisee Reclus
Historia de un arroyo
$35.190
$31.671 


Martti Nissinen
La profecía en la antigüedad
$113.135
$101.822 


Helen Czerski
La máquina azul
$45.699
$41.130 


Federico Miyara
Acústica y sistemas de sonido
$47.000
$42.300 


López, Guevara y otros
Los alimentos mágicos de las culturas indígenas mesoamericanas
$33.000
$29.700 


Feynman, Leighton y otros
Lecciones de física de Feynman I
$79.000
$71.100 


Weinersmith, Weinersmith
Una ciudad en Marte
$49.999
$45.000 


Alain Aspect
Si Einstein lo hubiera sabido
$45.699
$41.130 


Cabezas, Acosta
Cacapedia
$28.000
$25.200 


Paul Strathern
Bohr y la teoría cuántica
$20.900
$18.810 


Tarancon, Valle
Premoniciones
$37.000
$33.300

Manuel Espinosa Urgel
La vida social de las bacterias
$28.000
$25.200 


Analía Furio
Mal dormidos
$39.900
$35.910 


Hebe Vessuri
Conocimientos, sociedades y tecnologías en América Latina
$29.000
$26.100 


Fernando Valladares
Las pandemias
$27.100
$24.390 


Mercedes Ferrer Gijón
Megatsunamis
$29.800
$26.820 


Pedro Meseguer
Ficciones con ciencia
$33.900
$30.510 


Lucy Cooke
Hembras
$49.500
$44.550 


Castro, Huertas
La ciencia y la cocina
$29.800
$26.820 


Elena Campos Sanchez
Que sabemos de nuestro sistema inmunitario
$29.800
$26.820 


Cat Bohannon
Eva
$59.900
$53.910 


Gabriela Arriagada
Los sesgos del algoritmo
$20.000
$18.000 


Matthew Cobb
Una historia de la idea del cerebro
$40.900
$36.810 


Carlos Pedros-Alio
Biodiversidad
$40.700
$36.630 


Elisee Reclus
Historia de un arroyo
$35.190
$31.671 
